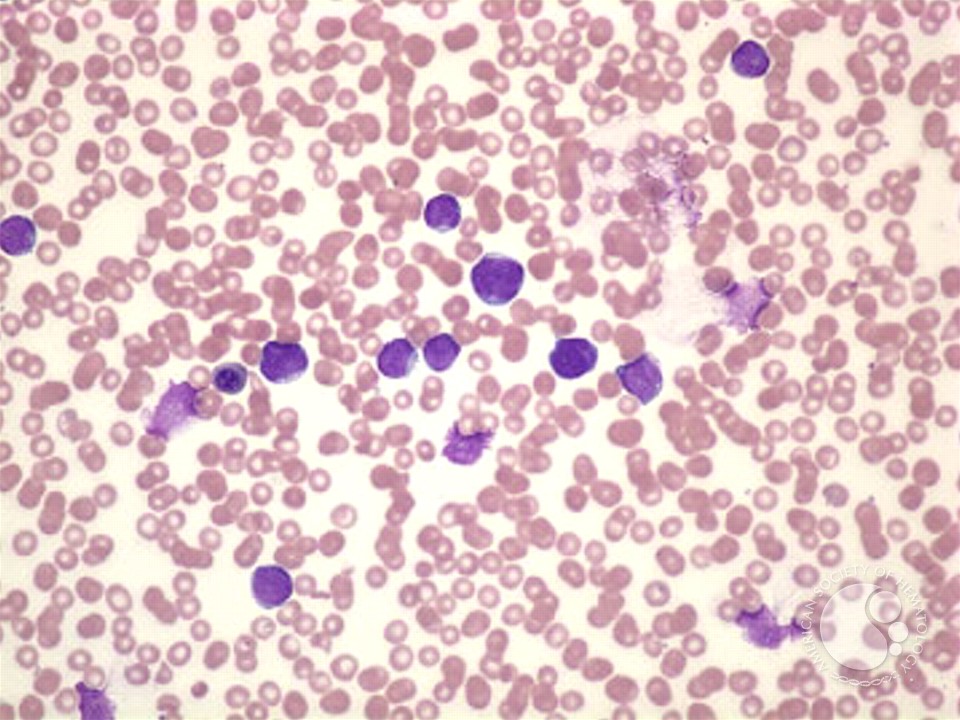
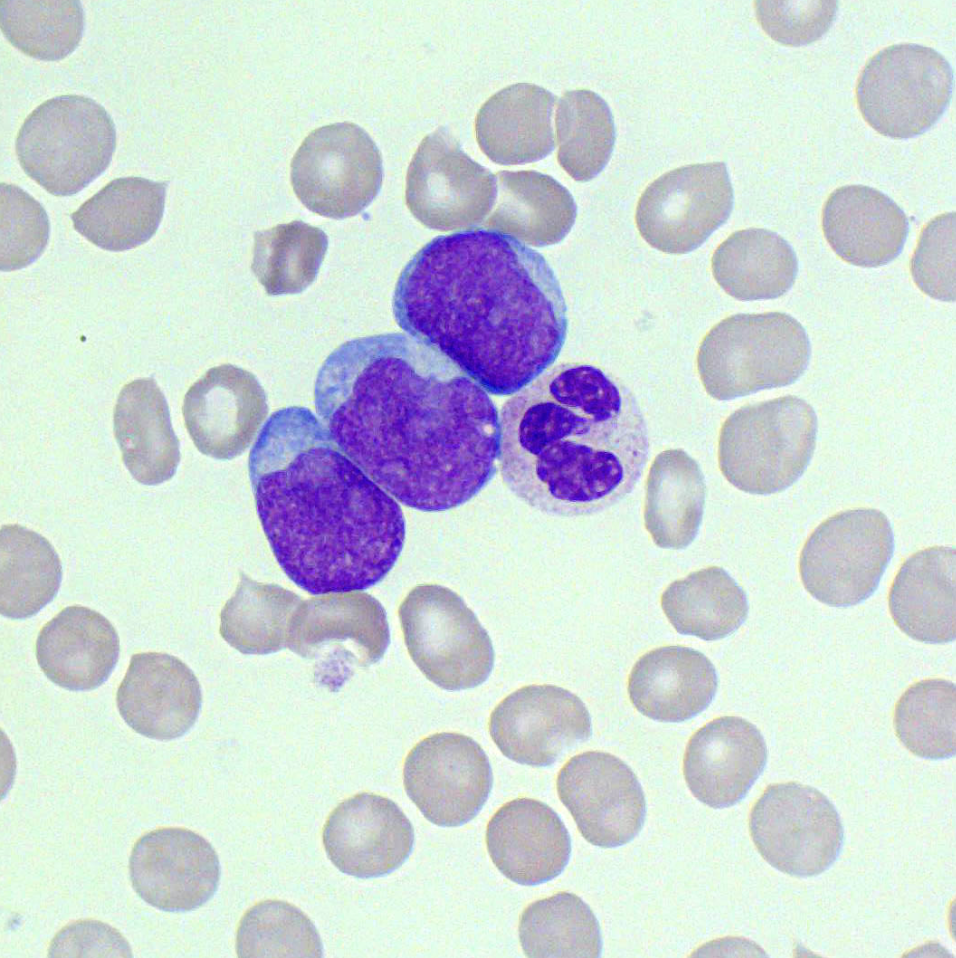

Mr. Ashok is a 45-year-old male who notes weakness and lethargy with progressive weight loss of nearly 3 kg over the past 3 weeks, accompanied by fever and night sweats.
History
Ashok has generally been well and active before this. The symptoms only appeared over the past 3-weeks and has become progressively worse, especially within the past one week. He had visited his local general practitioner a week earlier, where he was prescribed paracetamol and some antibiotics.
Over the past two days, he also notes a dull aching pain over his ribcage and sternum. In addition, he has noted some dark patches over both of his calves which appears like bruising. No epistaxis, gum bleeding or rectal bleeding was reported. He also finds it difficult to climb stairs, even at home due to lethargy and shortness of breath. He had no complaints of chest pain, coughing or lower limb swelling.
Ashok is vegetarian but consumes eggs and milk. He notes loss of appetite especially over the past one week. No other gastrointestinal symptoms such as abdominal pain, bloating, vomiting or diarrhoea was reported. No neurological symptoms such as headache, confusion or visual blurring was noted.
Ashok has no previous medical history of significance. He goes for regular annual medical check-ups, with no medical issues identified previously. He is not on any medications. He works as a software engineer, married and lives together with his wife and a teenage son in Kuala Lumpur. He is a non-smoker, claims occasional alcohol use. denies drug abuse and is financially stable.
Physical examination
Ashok was alert but looked frail and tired. His nutritional status looked satisfactory. There was no pallor, jaundice, cyanosis or clubbing.

A few petechial rashes and bruising was noted over the lower limbs. No retinal bleeds were however noted. Sternal tenderness could be elicited.
His weight was 76kg with height of 176cm. His vital signs were: PR: 82/min, BP: 150/80mmHg, RR: 16/min and temperature of 38oC.
Oral examination showed no abnormalities or bleeding. No peripheral lymphadenopathy was noted. Cardiovascular examination showed normal heart sounds with no murmurs. Lungs appeared clear.
No palpable masses were detected on abdominal examination. The liver was however enlarged, 1cm below the costal margin and the spleen was tipped. No neurological abnormalities were elicited.
Tasks (Part I) – hypothesis generation
- List three possible diagnosis in order of likelihood (principal diagnosis and differential/other diagnosis).
- For each possible diagnosis listed, provide findings from the history and clinical examinations or patient risk factors that would support your diagnosis.
- For each possible diagnosis listed, provide findings opposing the hypothesis, or findings that were expected but not present or elicited during the clinical examination.
- Based on your reasoning above, decide on the first-line laboratory and imaging tests that you would want to perform in the patient. For each test, state how the results may help you to affirm or disprove your hypothesis.
Investigations (first-line)
Haematology & Clinical Chemistry
| Reference range | Units | ||
| Full blood count | |||
| WBC | 21.6 | 4.0 – 11.0 | 109/L |
| RBC | 3.2 | 3.8 – 4.8 | 1012/L |
| Hb | 98 | 120 – 160 | g/L |
| Hct | 0.31 | 0.37 – 0.47 | |
| MCV | 96 | 77 – 97 | fL |
| MCH | 31 | 27 – 32 | pg |
| MCHC | 315 | 315 – 345 | g/L |
| RDW | 12.8 | 11.5 – 15.0 | % |
| Platelet | 53 | 150 – 400 | 109/L |
| Total white differential counts | |||
| Neutrophils | 1.3 (6%) | 2.0 – 7.5 | 109/L |
| Lymphocytes | 1.5 (7%) | 1.5 – 4.0 | 109/L |
| Monocytes | 0.9 (4%) | 0.7 – 1.5 | 109/L |
| Eosinophils | 0.01 | 0.3 – 0.8 | 109/L |
| Basophils | 0.01 | 0.02 – 0.1 | 109/L |
| Metamyelocytes | 4% | ||
| Myelocytes | 3% | ||
| Blasts | 76% | ||
| NRBC | 3/100 WBC | ||
| Serum electrolytes | |||
| Sodium | 135 | 135 – 148 | mmol/L |
| Potassium | 5.2 | 3.5 – 5.5 | mmol/L |
| Chloride | 99 | 95 – 105 | mmol/L |
| Calcium | 2.0 | 2.1 – 2.7 | mmol/L |
| Magnesium | 0.8 | 0.7 – 1.0 | mmol/L |
| Urea | 4.8 | 2.5 – 6.5 | mmol/L |
| Creatinine | 123 | 45 – 120 | mmol/L |
| Coagulation screen | |||
| PT | 14 | 11 – 15 | seconds |
| INR | 1.1 | 0.9 – 1.1 | |
| APTT | 33 | 25 – 35 | seconds |
Peripheral Blood Film

Red cells are reduced and appear normochromic normocytic. No significant anisopoikilocytosis or polychromasia is noted. NRBCs are present.
Platelets are reduced in numbers. White cells show neutropenia with left shifted maturation. Most of the cells see are composed of blasts with scanty bluish cytoplasm and occasional conspicuous nucleoli.
Impression: Leucoerythroblastic picture with features suggestive of acute leukemia. A bone marrow examination would be advised.
Tasks (Part II) – information integration and interpretation
- Refine your diagnosis based on the results of the investigation and reprioritise if necessary
- Formulate the next steps in investigation for confirmation of diagnosis, patient assessment prior to treatment initiation and prognostication
Investigations (additional)
Haematology – bone marrow examination



The lymphoblasts express B-lineage markers CD19, CD20, CD22, immature markers CD34, TdT, CD10, and aberrant CD25. They are aberrantly dim for CD38 and CD81. Immunophenotypic features is consistent with a B-lymphoblastic leukemia.

RT-PCR for ALL associated fusion transcripts
| E2A::PBX1 | Not detected |
| KMT2A::AFF1 | Not detected |
| ETV6::RUNX1 | Not detected |
| mBCR::ABL1 | Detected (p190 transcript) |
Tasks (Part III) – mechanistic diagram and management
- Develop a mechanistic diagram outlining the scientific mechanisms behind the major signs, symptoms and laboratory results seen in the patient
- Develop a basic care plan for the patient which should address the physical, mental, and social wellbeing needs of the patient